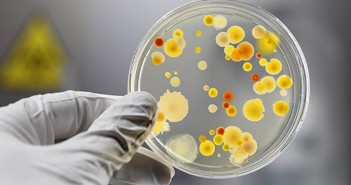

Che cos’è il mercato del lavoro?
“Gentile redazione, sulle vostre pagine e non solo siu fa un gran parlare di ‘mercato del…

“Gentile redazione, sulle vostre pagine e non solo siu fa un gran parlare di ‘mercato del…

Non chiamateli più bamboccioni: i giovani italiani, appena diplomati, sono già alla ricerca del primo…

L’outplacement, termine inglese che in italiano è stato tradotto in “supporto alla ricollocazione di personale”,…

Uber, società americana leader nel settore del noleggio con conducente, e Jobyourlife, piattaforma italiana di…

348.000 donne in Italia sono dipendenti nel settore della ristorazione e dei bar. Una delle…

Per la prima volta da lungo tempo cresce il numero di contratti a tempo indeterminato:…
C’è lavoro per i biologi oggi in Italia? L’Ordine Nazionale dei Biologi (ONB) crea una…

Quali sono le professioni più richieste nel 2015? Ce lo dice l’ISFOL, l’ente del Ministero…

Dal 10 novembre 2014 sarà possibile presentare domanda online per gli incentivi alle assunzioni in…

Il Jobs Act farà ripartire il lavoro? E’ quello che si chiedono sia i promotori,…